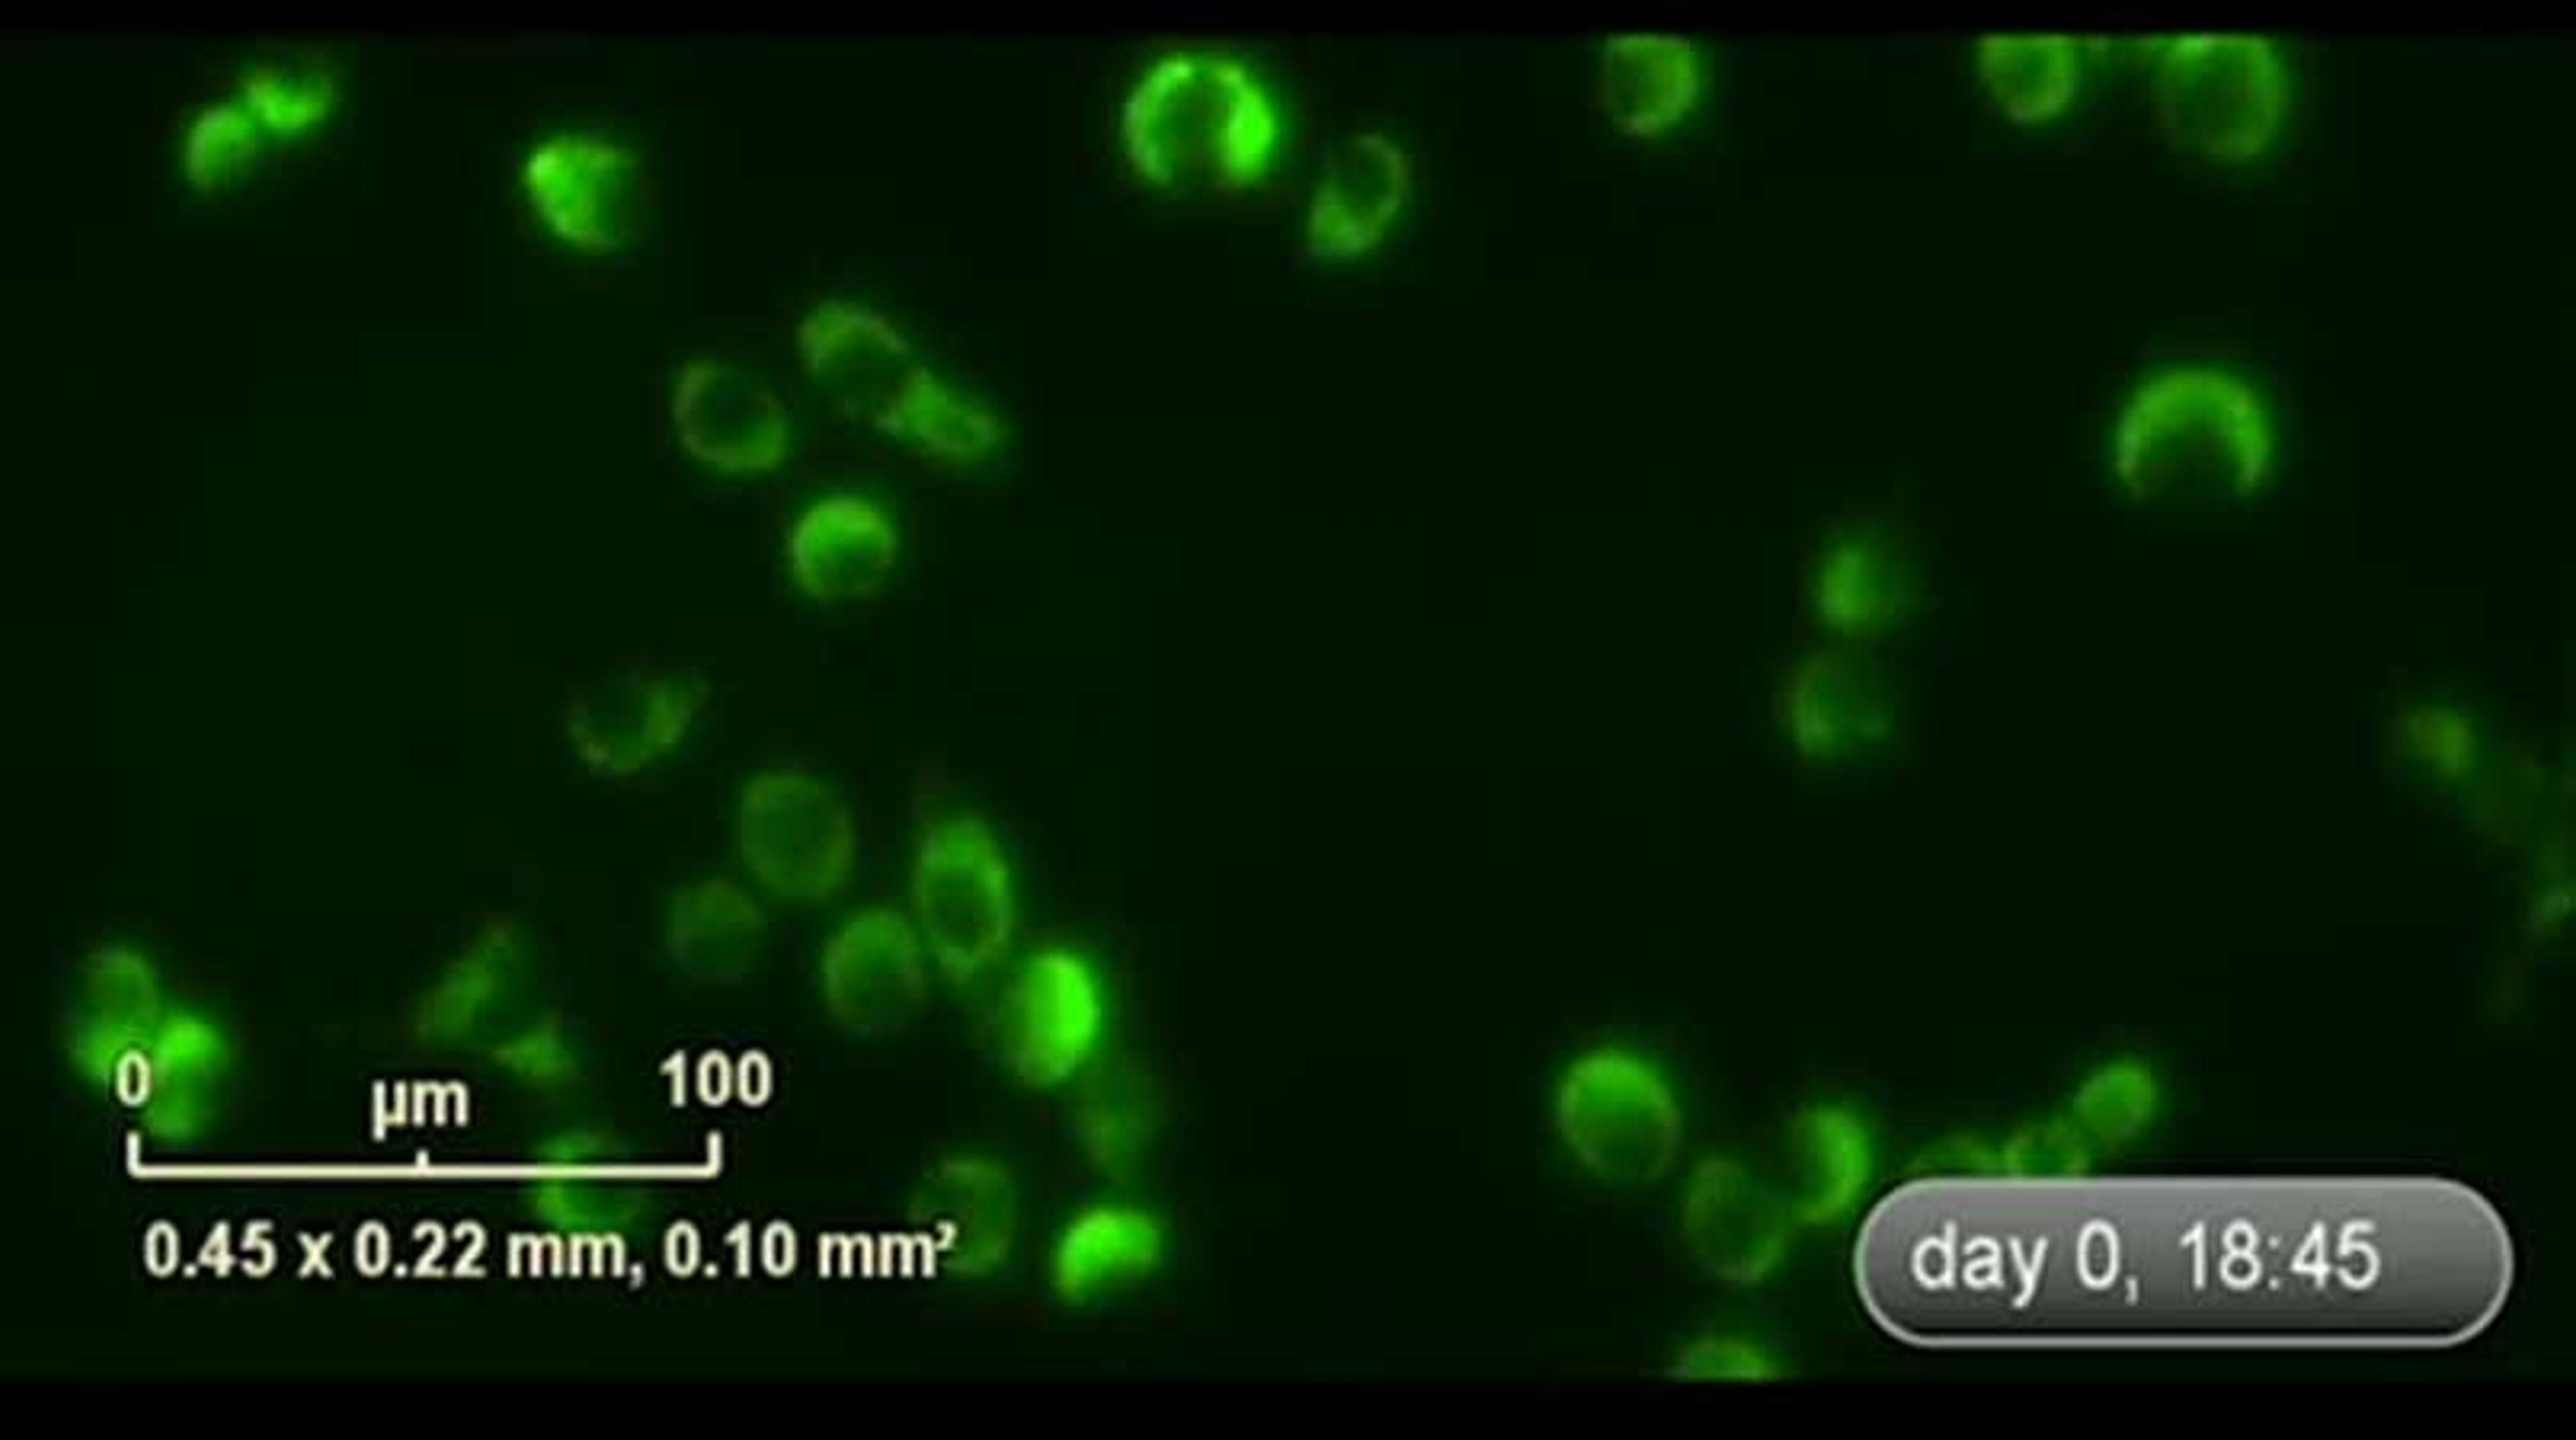

Incucyte® Live-Cell Analysis Systems
Incucyte ® , Empower Live-Cell Analysis Inside Your Incubator
Fluorescence cell count
Virology assays
Simply love this microscope. It is the best that I ever used for fluorescence. The fluorescence cell count is the best!
Review Date: 10 Mar 2025 | Sartorius Group
Transforming Cancer Drug Research with the Incucyte
Cancer Research
As a cancer researcher focused on developing and optimizing drug therapies, the Incucyte has revolutionized the way I track cancer cell behavior, assess drug efficacy, and uncover new therapeutic candidates. Traditional endpoint assays provide only static snapshots of cellular responses, often missing critical dynamic changes. The Incucyte overcomes this limitation by enabling real-time, continuous imaging of live cells, allowing for kinetic analysis of drug effects over days or even weeks. The system’s ability to capture both phase-contrast and fluorescence imaging in a label-free or labeled manner has been particularly valuable in monitoring cancer cell proliferation, apoptosis, and migration. I can now directly observe how drug-treated cells respond over time, rather than relying solely on indirect biochemical assays. This has been crucial in identifying dose-dependent responses, resistance mechanisms, and combination therapy synergies with unprecedented precision. Moreover, the automated data analysis tools streamline quantification, reducing variability and increasing reproducibility across experiments. With its non-invasive imaging approach, I can test multiple conditions simultaneously, improving throughput and accelerating drug discovery. The Incucyte has fundamentally changed how I conduct cancer drug research, providing deeper insights into treatment efficacy and enabling faster, more informed decisions in the development of novel cancer therapies.
Review Date: 12 Feb 2025 | Sartorius Group
Great results
Chemosensitivity testing for chemotherapy guidance
Easy to use software with good feature for cell identification and gives very proper guidance live and dead cell discrimination.
Review Date: 16 May 2024 | Sartorius Group
Great piece of machine that frees up our time to do other research
Live cell imaging
The IncuCyte has been invaluable in our research and more and more people are wanting to use. It now has many modules that increases its capabilities. It isn't without any issues but when it happens, we have great service person coming onsite to fix.
Review Date: 6 Jun 2023 | Sartorius Group
Great Instrument...
Cell Proliferation check by using BF, GFP,RFP
The instrument and its software are straightforward to use. Its pic resolution is also suitable for work and publication. Their current price change is high, which sometimes causes a brainstorm before buying any product.
Review Date: 30 May 2023 | Sartorius Group
Using this system is a step forward to great discovery.
Analyze antibody or homing peptide-therapeutic agent internalization
The product is very effective for studying the internalization of complexes and also allows you to get highly reproducible results It is easy to use and has a convenient after-sale care. The cost of money is acceptable compared to the achievements obtained.
Review Date: 30 May 2023 | Sartorius Group
Great Results, Very much satisfactory
Analysis of Live Tissues
The Incucyte® Live-Cell Analysis System is truly a game-changer in the field of cell biology research. I have had the opportunity to work with this system and I must say, it has revolutionized the way we study live cells.The user interface of the Incucyte® software is intuitive and user-friendly. Setting up experiments and analyzing data is a breeze, even for those who may not have extensive experience with imaging systems. The system provides robust and reliable data, enabling us to make informed decisions and draw meaningful conclusions from our experiments.Overall, the Incucyte® Live-Cell Analysis System has transformed the way we study live cells. Its real-time monitoring capabilities, user-friendly interface, versatility, and productivity-enhancing features make it an indispensable tool for cell biologists. I highly recommend this system to anyone seeking to gain deeper insights into cellular dynamics and behavior.
Review Date: 30 May 2023 | Sartorius Group
Great results, high capicity
Accurate cell counting is a critical step across a spectrum of cell biology applications
This system is designed to efficiently capture cellular changes where they happen - in the incubator. Capture high-resolution fluorescence and bright field images and record data in real-time over hours, days, or weeks, with key features: Never miss a data point with real-time continuous analysis, profile cell-specific and time-dependent biological activity and visualize and validate results with images and movies.
Review Date: 30 May 2023 | Sartorius Group
Excellent device
Live imaging
Very efficient high through-put live imaging device, efficient software, still with some limitations about the number and locations of frames taken. With every new update, it is being solidly improved.
Review Date: 29 May 2023 | Sartorius Group
Standardized and reliable results
Real time tissue culture control
Effective and efficient, it also provides real-time data on the behavior of cells in culture together with the reduction of error due to trypsinization, operator change, and reading subjectivity. It is simply fabulous
Review Date: 29 May 2023 | Sartorius Group
Incucyte® Live-Cell Analysis Systems automatically acquire and analyse images around the clock, enabling you to derive deeper and more physiologically relevant information about your cells, plus real-time kinetic data — without ever removing your cells from the incubator.
Change can happen in an instant. Whether simply assaying cell health or more complex processes like migration, invasion, or immune cell killing, see what your cells are doing and when they do it. Incucyte® instruments, proprietary assays and reagents provide you with the ability to gain new insights into biological processes via real-time, quantitative analysis of live cells.
Conventional approaches to cell analysis only capture a single time point, enabling only single-point and end-point measurements, and cells are perturbed or destroyed as part of the assay process. Incucyte® systems offer the advantage of performing live-cell analysis without ever having to displace cells or disrupt their surroundings. The system automatically and continually collects and analyzes images throughout the course of an experiment while cells remain unperturbed in a physiologically relevant environment. Furthermore, Incucyte® accommodates multiple users and applications seamlessly and combines information-rich, image-based analysis with the convenience and throughput of microplate assays.
Incucyte® technology is featured in over 3,000 peer-reviewed publications in journals such as Nature, Chemical Society Reviews, Nature Medicine, and Nature Genetics, among many others. Incucyte® offers a completely reimagined user interface, enabling even first-time users to set-up an experiment and begin acquiring images within minutes. Image viewing, analysis and graphing is similarly streamlined – images from a 96-well experiment can be viewed simultaneously, then converted into movies, metrics, and corresponding publication- and presentation-ready graphs with just a few clicks. In addition to improving productivity for the individual user, Incucyte® empowers an entire research team. Multiple users can run multiple applications on the Incucyte® in parallel, reducing time spent waiting for an instrument to be available.
In addition, data is accessible remotely to any user via unlimited, free networked licenses. Incucyte® and its unique features provide a powerful platform that enables researchers to devise new experiments not previously thought possible. In addition to Incucyte® platforms, Incucyte® proprietary reagents and analysis software are also available which enable researchers to perform real-time, quantitative live-cell analysis and evaluate a wide variety of cellular processes over time.
Never miss powerful insights again, with Incucyte® Live-Cell Analysis Systems, reagents, and consumables.
Key Features of Incucyte® Live-Cell Analysis Systems:
Ask new questions
- Devise new experiments not previously possible
- Conduct routine monitoring and get answers to unique scientific questions with kinetic, image-based measurements
Get new answers
- Never miss a data point with real-time continuous analysis
- Profile cell-specific and time-dependent biological activity
- Visualize and validate results with images and movies
Improve productivity
- Enjoy walk-away convenience as images are automatically acquired and analyzed
- Multiplex measurements in 96- and 384-well assay formats
- Accommodate multiple users and applications simultaneously
Protect your cells
- Perform analysis without ever removing cells from the incubator or disturbing cultures
- Maintain cell health and morphology with non-perturbing reagent formulations
Applications:
- Monitor metabolism in cancer cells
- Complex immune-tumor cell interactions
- Synaptic activity in neuronal co-cultures
- Proliferation (confluence and cell counts)
- Apoptosis (caspase 3/7 for live-cell imaging)
- Cytotoxicity
- Dilution cloning (whole-well imaging)
- Migration / Invasion
- Stem cell monitoring and reprogramming
- 3D-Spheroids Angiogenesis
- Neurite outgrowth and dynamics
- Neuronal Activity
- Reporter gene expression
- Viral studies
- Immune response – Immune cell killing
- Antibody Internalization
- NETosis
- Phagocytosis
- Immune cell clustering
- Immunocytochemistry
- Cell-by-Cell Analysis
- Cell culture (& QC)
Brochures
Empower live-cell analysis inside your incubator
In this brochure, Sartorius introduce the Incucyte® Live-Cell Analysis Systems and accessories.
Find out how Incucyte’s user-friendly interface and robust instrument portfolio, can enable you to gain dynamic insights into the health, morphology, movement and function of your cell models in the stable environment of your culture incubator.
Real-Time Visualization and Quantification of Neutrophil Extracellular Traps
Expulsion of extracellular traps is a defense mechanism utilised by neutrophils upon contact with microbes. Extracellular Traps are formed of DNA and antimicrobial proteins including myeloperoxidase (MPO) and neutrophil elatase (NE). This poster describe a simple kinetic live-cell imaging approach using a combination of phase and fluorescence imaging to visualise stages of neutrophil extracellular trap (NET) formation.
Evaluating antibody–drug conjugates (ADCs) in vitro using 3D tumor spheroid models
Antibody–drug conjugates (ADCs) combine highly targeted delivery of chemotherapeutic drug molecules with an immunotherapeutic intervention for cancer cell killing. A rapid increase in ADC development in recent years has created a need for robust and reliable techniques for assessing novel candidate drugs. The use of 3D advanced cell models can improve the translational ability of these in vitro techniques. In this application note, Sartorius presents a combined Incucyte® Live-Cell Analysis and iQue® High-Throughput Screening (HTS) by cytometry workflow for assessing anti-HER2 ADC activity in single and multi-spheroid models. Incucyte Live-Cell Analysis data demonstrated greater induction of cytotoxicity by anti-HER2 ADCs (Kadcyla® and Enhertu®) compared to the monoclonal antibody (mAb) backbone on which they were based (trastuzumab).
Applications of morphometry in live-cell analysis
Cell morphology is one of the strongest indicators of cell health. However, there is no current consensus on exactly how cell morphology should be quantified. Incucyte® Live-Cell Analysis Systems enable cells to be visualized from within an incubator over long periods of time. This application note dives into the various applications of morphometry in live-cell analysis.
AI-driven label-free image analysis for assessing chemotherapeutic cytotoxicity in glial cells
In this application note, Sartorius demonstrates a robust in vitro assay using the Incucyte® Live-Cell Analysis System and AI-driven analytics to assess the cytotoxic effects of chemotherapeutics in glioblastoma multiform (GBM) cells. The study shows concentration-dependent effects across different glial cell types and highlights the system's potential for screening therapeutic candidates. The Incucyte system offers automated analysis, accurate cell segmentation, and live/dead classification, making it a powerful tool for studying cytotoxicity in glial cells.
Label-free imaging and kinetic analysis in live cells
In this white paper, Sartorius describes recent developments in software tools for label-free analysis on the Incucyte® Live-Cell Analysis System, namely the Incucyte® Cell-by-Cell Analysis Software Module for uni-variate analysis, Incucyte® Advanced Label-Free Classification Software Module for multi-variate analysis, and Incucyte® AI Confluence Analysis. This software module uses a neural network, a type of deep learning associated with artificial intelligence (AI). Sartorius demonstrates how these tools can be applied for label-free kinetic analysis in routine culture assays.
Advanced label-free classification of cell morphology subpopulations
In this application note, Sartorius describes how label-free image analysis can be used to derive morphological data using Incucyte® Advanced Label-free Classification. This versatile software module enables the quantification of user-defined morphological subpopulations over time.
Revolutionary insight into cancer hallmarks with real-time live-cell analysis
This white paper discusses the research that is now underway thanks to Sartorius' improved understanding of cancer hallmarks and how the latest technological advances support this research.
Four steps to cell-based analysis in advanced cell models
In this infographic, the challenges and opportunities presented by increasingly popular cell-based analysis in advanced cell models are considered, with live-cell monitoring via the Incucyte® from Sartorius offered as a solution to help explore and analyze these complex cell models. With precious samples requiring active management, real-time information supports a better understanding of the biological processes at play. This infographic presents the key advantages of live-cell analysis to optimize cultures, capture rare events and enable better decision-making in your experimental workflows.
COVID-19 vaccine research challenges and solutions
Accounting for at least 15% of all human pathogens, emerging infectious diseases (EID) pose a significant burden on public health. Vaccination represents one of the most successful prophylactic tools for disease prevention and control, however, the development process is typically lengthy and expensive. While there has been a rapid development of multiple safe and highly effective vaccines in response to the current COVID-19 pandemic, there are still many challenges to overcome. This application note will explore the common challenges of vaccine development and the solutions available to overcome them.
Live-cell imaging & analysis: Capture important cellular events in live-cell assays
Within heterogeneous culture systems, important cellular events are often missed that, if detected, could give a whole new level of biological insight. In this infographic, discover an automated platform that combines lab-tested protocols and reagents with powerful, automated image acquisition and analysis.
Ultimate guide to cell health assays
Measuring cell health is essential for studying the effects of drugs, culture conditions or genetic modifications on cell growth or viability.
In our latest eBook, we provide a comprehensive guide to the use of live-cell assays for the real-time monitoring and analysis of cell health.
From cell proliferation to apoptosis and cytotoxicity assays, explore how this approach can deliver novel insights at an unprecedented speed, depth and scale, and learn how to apply it to your research.
Live-cell imaging for label-free toxicology analysis of hepatic organoids
Conventional 2D cultures of primary hepatocytes or established hepatic cell lines do not provide a true representation of the cellular mechanisms observed in vivo. In this webinar we will demonstrate an efficient and consistent protocol developed by STEMCELL Technologies to extract, grow, and differentiate liver cells in a complex 3D organoid culture system. These organoids more closely resemble the human liver and can be used in standard and high throughput assays to accommodate both academic and industry research needs.
This webinar will demonstrate the use of hepatic organoid cultures to validate a label-free live-cell toxicology screen using a powerful and flexible Incucyte® Live-Cell Analysis System.
Key learning objectives
- Organoid cultures – from tissue to mature 3D organoid culture and their downstream analysis
- Real-time kinetic analysis of organoids
- Label-free live-cell toxicology screening
- Key challenges of compound validations and data interpretation to improve the efficacy of drug discovery workflow
Who should attend?
Both academic and industry researchers using 3D in vitro models.
Certificate of attendance
All webinar participants can request a certificate of attendance, including a learning outcomes summary, for continuing education purposes.
Real-time visualization and quantification of Akt activity using live-cell imaging
Kinase signaling plays a key role in coupling extracellular stimuli with numerous downstream cellular functions including proliferation, survival, and migration. These pathways are highly interconnected, and their dysregulation has been implicated in several disease processes, including cancer initiation and metastasis, and chronic inflammation. Akt is a serine/threonine protein kinase that is upregulated across various diseases and has been extensively studied as a therapeutic target. Studying dynamic changes in kinase activity can be difficult, with standard approaches being limited to endpoint assays which cannot monitor the effects of treatment over time.
In this webinar, John Rauch, senior scientist at Sartorius, and Jasmine Trigg, scientist at Sartorius, will demonstrate the utility of the Incucyte® Kinase Akt Lentivirus Reagent, encoding a kinase translocation reporter based on a green fluorescent protein-tagged Akt substrate whose subcellular localization is phosphorylation-dependent, and a red fluorescent nuclear protein to denote the nuclear/cytoplasmic boundary. This biosensor enables Akt activity to be monitored in real-time, providing kinetic data on Akt activation and inhibition in living cells within a physiologically relevant environment.
Key learning objectives
- Gain an overview of validated assays combining the Incucyte® Kinase Akt Lentivirus Reagent and the Incucyte® Live-Cell Analysis System for image-based fluorescent readouts of Akt activity.
- Discover guidance on experimental set-up and how live-cell analysis can be built into your development workflow.
- Learn about case study data to support the use of live-cell analysis within the fields of oncology, inflammation and neuroscience.
Who should attend?
- Researchers involved in fundamental research and therapeutic development.
- Scientists interested in quantifying Akt activity, and its modulation, within the fields of oncology, inflammation, and neuroscience.
- Individuals who desire to implement live-cell imaging into their workflow.
Certificate of attendance
All webinar participants can request a certificate of attendance, including a learning outcomes summary, for continuing education purposes.
New Incucyte CX3 is a "game-changer" for advanced 3D cell analysis
Discover how the new Incucyte® CX3 from Sartorius is advancing 3D cell analysis through high-throughput imaging and seamless workflow integration. In this interview, Lindy O’Clair, Incucyte® Product Manager at Sartorius, shares insights into the innovations powering the CX3 and how it’s helping researchers generate richer, more reliable data with ease. Explore the future of live-cell imaging and analysis with Sartorius here.
This video was filmed at SLAS Europe 2025.
How Sartorius is advancing global health through innovation
With 155 years of industry experience, innovation is in Sartorius' DNA. In this interview, Dr. Alexandra Gatzemeyer, Head of the LPS Division and Executive Board Member at Sartorius, highlights the importance of the company's latest technology releases. She explains how these advancements align with emerging trends in research and therapeutics and describes what a successful partnership with Sartorius looks like in practice.
This video was filmed at SLAS Europe 2025.
Label-free quantification of cell growth and morphology
Discover a powerful approach to live-cell imaging and intuitive label-free analysis, learn more about building a non-perturbing, unbiased AI into your workflow. Incorporating Artificial Intelligence (AI), and data-science based algorithms, into user-friendly workflows has enabled powerful quantification of a wide range of cellular models. Explore how the Incucyte® Live-Cell Analysis System provides an ideal platform to study multifaceted biological paradigms in drug discovery.
Strategies for simplifying viral vaccine and biotherapeutic discovery
Watch this presentation by Allan Schell, David Apiyo, and Victoria Yatsula, titled: Strategies for simplifying viral vaccine and biotherapeutic discovery. This talk was presented at the SelectScience® Virtual Microbiology and Infectious Disease Summit 2022.
Evaluation of glioblastoma radiotherapy & drug combinations with live-cell analysis
In this case study, researchers from the University of Glasgow explain how they use the Incucyte Live-Cell Analysis System to evaluate the short- and long-term effects of radiotherapy and drug combinations on glioblastoma and normal brain cells.
Evaluation of lung phenotypic models with live-cell analysis to identify treatments for COVID-19
In this case study, Professor Neil Carragher from the University of Edinburgh will discuss how he uses live-cell analysis to study inflammatory and primary lung phenotypic models to identify treatments for COVID-19.
Quantify Cell Heterogeneity with Real-Time Live-Cell Analysis
Achieve automated image capture of heterogeneric cellular populations in real time with the IncuCyte® Live-Cell Analysis System by Sartorius, and its powerful Cell-by-Cell Analysis application.
This interview was filmed as part of our coverage of AACR 2019 - see other video highlights here >>
Sartorius Wins Silver Seal of Quality at Neuroscience 2018
The 2018 SelectScience Silver Seal of Quality win by Sartorius is a testament to the hard work by the product development team, says Dr. Daniel Appledorn of Sartorius. The IncuCyte S3 Live-Cell Analysis System by Sartorius has earned over 100 reviews left by scientists from around the world.
Key cell biology lab products reviewed by our scientists
From everyday reagents to state-of-the-art tech, find reviews on a range of cell biology lab products and services
4 upcoming webinars to accelerate your research
Discover the latest tools and techniques to expand your research capacity with expert-led presentations on drug discovery, metabolomics, clinical pathology, and more
Gaining the most insight from critical quality attribute measurements
Live-cell analysis can help ensure the efficacy of your critical quality attribute measurements
Classification of cell morphology with advanced multivariate analysis
Watch this on-demand webinar to discover a user-friendly workflow that yields quantitative analysis of a wide range of biological models
Discover the ultimate guide to live-cell imaging
Download our new eBook with all the resources and expert advice you need to choose the best microscopy equipment for your cell analysis applications
3D cell culture: Discover the latest technologies and resources for your research
Hear from leading experts and explore tools to advance your work using 3D cell culture
Sartorius releases the 5th Edition of its popular Live-Cell Analysis Handbook
Including a new section for embedded organoid assays, and new data on mitochondrial membrane potential assays and phagocytosis assays
Evaluation of checkpoint inhibitor therapies using a mixed lymphocyte reaction (MLR) assay
Watch this on-demand webinar to learn how the iQue® Advanced Flow Cytometry Platform and associated reagent kits can be used to quantify T cell response in MLR
Striving for greater clinical relevance in intestinal organoid culture
Learn how a Canadian biotechnology company is harnessing cutting-edge real-time cell imaging to improve physiological relevance in intestinal organoids
Improving organoids to advance understanding of lung development and disease
Dr. Sandra Leibel, USCD and Rady Children’s Hospital, discusses physiologically relevant lung organoids, the power of automated live-cell imaging and the search for new biotherapeutics
Product Overview
Links
Products Model Information
Incucyte® S3 Live-Cell Analysis System
Sartorius GroupOur flagship, supports the workflow and workload of larger laboratories.
Incucyte® SX5 Live-Cell Analysis System
Sartorius GroupLeading the Way With Living Cells, our most advanced application offering.